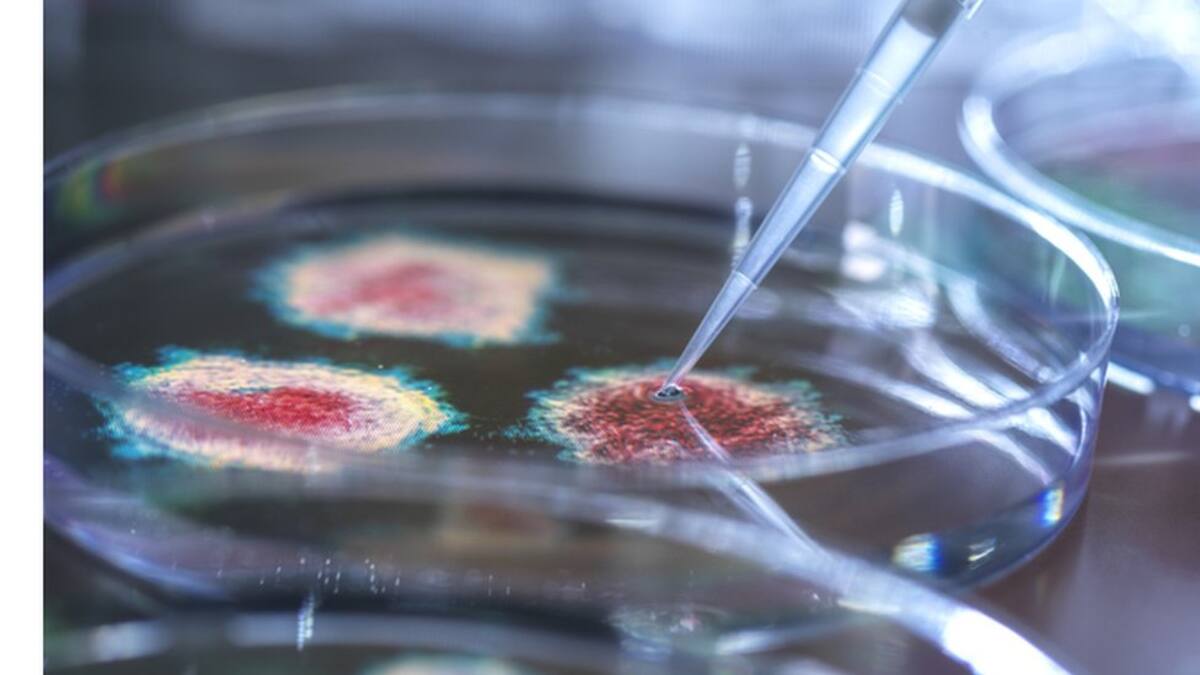

Vacunas contra covid-19: la carrera por lograr una vacuna "pancoronavirus", que proteja contra todas los variantes de coronavirus (y las que puedan llegar a exisitir)
En tiempo récord se fabricaron vacunas contra el SARS-CoV-2, ahora el desafío es lograr una que combata toda la familia de coronavirus. Los investigadores son optimistas.



"Un bicho, una droga".
Entre los científicos de la salud, esa es una frase común para referirse a una tradicional forma de trabajar: cada vez que surge una nueva enfermedad, intentan desarrollar un tratamiento, un medicamento o una vacuna para combatir específicamente esa dolencia.
Así ocurrió con el SARS-CoV-2, el coronavirus que causa la enfermedad covid-19.
En tiempo récord, científicos en varias partes del mundo desarrollaron vacunas que protegen a las personas contra ese virus en particular.
Ese fue un maravilloso logro de la ciencia, pero tiene al menos tres limitaciones.
La primera es que las mutaciones que generan nuevas variantes del virus en algún momento pueden disminuir la eficacia de las vacunas, o incluso escapar de la respuesta inmune que producen.
La segunda es que el SARS-CoV-2 es solo uno de al menos siete tipos de coronavirus que se saben que pueden afectar a los humanos.
Y la tercera es que situaciones como la destrucción de hábitats naturales y el avance humano hacia territorios salvajes, aumenta la interacción entre humanos y animales, lo cual eleva las posiblidades de que un coronavirus animal pase a las personas.
Por razones como estas, los científicos coinciden en que es muy probable que en el futuro el mundo vuelva a enfrentarse a una nueva epidemia de coronavirus.
Ese riesgo ha llevado a que varios investigadores, incluso antes de esta pandemia, hayan estado buscando una vacuna universal que pueda combatir varios, incluso todos los coronavirus que afectan a los humanos, y las variantes que existen o puedan llegar a existir.
Sería una poderosa vacuna "pancoronavirus".
Entonces ya no estaríamos hablando de vacuna para un solo bicho, sino una vacuna para muchos bichos.
¿En qué consiste este enfoque y qué tan factible es que una vacuna pancoronavirus se haga realidad?

La familia de los coronavirus
Los coronavirus son una familia de virus que comparten una característica: la corona, una proteína en forma de espiga que utilizan para infectar a las células del organismo donde se hospedan.
Hay cuatro tipo de coronavirus: alfa, beta, gamma y delta.
Entre ellos, hay siete que pueden infectar a los humanos, según explican los Centros para el Control de Enfermedades de Estados Unidos.
Y entre esos siete, hay tres del grupo beta que han causado epidemias en años recientes, según datos de la Organización de la Salud (OMS):
- El MERS-CoV, que causa el Síndrome Respiratorio de Oriente Medio (MERS). Se identificó por primera vez en Arabia Saudita en 2012. Hasta marzo de 2021, se han confirmado 2.574 casos de MERS, incluyendo 885 muertes
- El SARS-CoV, que causa el Síndrome Respiratorio Agudo Severo (SARS). Se identificó por primera vez en China en 2003. Durante ese brote se registraron 8.098 casos, incluyendo 774 muertes
- El SARS-CoV-2, que causa la covid-19. Identificado en China en 2019, hasta el 28 de abril había contagiado a casi 150 millones de personas, incluyendo más de 3,1 millones de muertes
"Relativamente fácil"
Hoy en varios laboratorios se desarrollan iniciativas para fabricar vacunas universales contra el coronavirus.
El rápido desarrollo de las vacunas contra el SARS-CoV-2 es una muestra de que quizás no sea tan difícil lograrlo, según los especialistas.
Una de las razones es la proteína de espiga.
Cuando esta proteína ataca a una célula, hace que se produzcan unos anticuerpos neutralizantes que se adhieren al virus e impiden que infecte a la célula.
Hasta ahora, ha resultado relativamente fácil que las vacunas contra el SARS-CoV-2 estimulen el desarrollo de esos anticuerpos neutralizantes.
Estos anticuerpos tienen la capacidad de actuar en distintas variantes de un mismo virus, y podrían usarse para diseñar vacunas que actúen contra varios miembros de una misma familia de virus, como es el caso de los betacoronavirus.

Además, hasta ahora el SARS-CoV-2 no ha mostrado una fuerte capacidad para evadir la respuesta inmune y la acción de los anticuerpos neutralizantes, según explican Dennis Burton y Eric Topol, investigadores de inmunología y medicina molecular del Instituto Scripps, en un artículo de la revista Nature.
Eso representa una ventaja respecto a otros virus como el de la influenza o el VIH, que tienen alta capacidad de producir variantes que les permiten escapar a la respuesta inmune.
Esa es una de las razones por las que aún no se ha logrado aprobar una vacuna contra el VIH; y por la que cada año es necesario actualizar la vacuna contra la influenza.
Otra señal alentadora viene de los sobrevivientes del SARS, según explica un reciente artículo de la revista Science.
En pruebas de laboratorio, se ha observado que los anticuerpos que desarrollaron estas personas pueden bloquear también la infección del SARS-CoV-2.
Con esos antecedentes, en comparación con la gripe y el VIH, desarrollar una vacuna pancoronavirus "será relativamente fácil", según dice con optimismo Barney Graham, subdirector de investigación de vacunas del Instituto Nacional de Alergias y Enfermedades Infecciosas de EE.UU. (NIAID), citado por Science.
Graham también estuvo involucrado en el desarrollo de la vacuna contra la covid-19 de la compañía Moderna.

Una contra todos
Hasta el momento, ninguna candidata de vacuna pancoronavirus ha sido probada en humanos.
Sin embargo, "en uno o dos años vamos a tener muchos resultados", según le dice a BBC Mundo la doctora María Elena Bottazzi, codirectora de la Escuela Nacional de Medicina Tropical del Colegio Baylor de Medicina de Houston y codirectora del Centro para Desarrollo de Vacunas del Hospital Infantil de Texas, en Estados Unidos.
En 2016, Bottazzi trabajó en una posible vacuna pancoronavirus, pero para entonces el SARS y el MERS habían dejado de ser una urgencia y surgieron otras prioridades como el ébola y el zika. Por esa razón no tuvo recursos para seguir con sus investigaciones.
Según Bottazzi, el desarrollo de una vacuna pancoronavirus es un trabajo en etapas.
Primero, se puede aspirar a lograr una vacuna contra todas las variantes de covid-19.
Luego, se puede ampliar para que la vacuna cubra todos los betacoronavirus, o incluso también los alfa, que también pueden infectar a los humanos.
Finalmente, se podría llegar a predecir secuencias del virus para desarrollar vacunas que cubran todos los coronavirus.
"Lo ideal sería una vacuna que cubra todos los coronavirus que están presentes en humanos", dice Bottazzi, "pero también predecir lo que podría ser otro coronavirus que va a causar un brote".
En busca de la vacuna
Según explica Bottazzi, hay dos caminos para fabricar una vacuna pancoronavirus.
Una opción es desarrollar varias vacunas individuales, llamadas monovolantes, que actúen sobre un coronavirus específico, y luego combinar varias vacunas monovalentes para lograr una sola vacuna polivalante, que actúe sobre varios tipos de coronavirus.

Esta es la tecnología que se utiliza, por ejemplo, en la vacuna pentavalente que protege a los niños contra la difteria, la tosferina, el tétanos, la poliomielitis e infecciones producidas por Haemophilus Influenzae tipo b.
La otra opción es encontrar un código genético que sea suficientemente representativo de los coronavirus, a partir del que se pueda crear una vacuna universal.
Una vez se logre alguna de estas vacunas, los laboratorios y farmacéuticas deberían evaluar si las producen y las tiene almacenadas para cuando se necesiten.
Otra posibilidad es no fabricarlas completamente sino avanzar en los estudios de seguridad y eficacia y, si llega a ocurrir la amenaza de una pandemia, comenzar a fabricarlas a partir del camino que ya se tiene avanzado.
El momento indicado
Ante el impacto de la covid-19, el desarrollo de una vacuna pancoronavirus se ha vuelto muy relevante.
En noviembre de 2020 el NIAID abrió una convocatoria de emergencia para otorgar fondos a proyectos de fabricación de vacunas pancoronavirus.
En marzo, la Coalición para Innovaciones en Preparación para Epidemias (CEPI, por sus siglas en inglés), una organización sin ánimo de lucro que trabaja en alianza con la OMS, anunció un fondo de US$200 millones para acelerar investigaciones en el desarrollo de vacunas contra los betacoronavirus.
Según la revista Science, actualmente en el mundo hay más de 20 equipos de investigación trabajando en una candidata a vacuna pancoronavirus.
Según CEPI, varias de estas iniciativas en principio lucen prometedoras.
Una de ellas es la colaboración entre la Universidad de Nottingham, la Universidad Nottingham Trent y la farmacéutica Scancell.
Su apuesta es por una vacuna que actúa sobre la proteína espiga y sobre otra estructura del virus, llamada proteína N.
Esa proteína N es mucho menos propensa a mutar, con lo cual, si la vacuna logra actuar sobre ella, podría generar una respuesta inmune sin importar que la espiga sí haya mutado.
De esa manera, podría ofrecer protección en varios tipos de coronavirus.
CEPI también destaca el proyecto del Instituto Tecnológico de California, donde se trabaja en una vacuna "todo en una".
Este prototipo consiste en utilizar una nanopartícula que sostiene fragmentos de la espiga de varios coronavirus.
En ensayos de laboratorio en febrero, este método mostró que puede generar anticuerpos contra varios tipos de coronavirus.
China y Cuba también trabajan en un proyecto conjunto para desarrollar una vacuna universal a la que han llamado "Pan-Corona", según informó la agencia EFE.
La técnica de esta candidata consiste en combinar fragmentos de distintos coronavirus, con el fin de generar una respuesta inmune que actúe sobre todos ellos.
Por ahora, "la urgencia es terminar de atacar el covid-19", dice Bottazzi, pero al mismo tiempo, dice que ella y los demás equipos de investigación trabajan en modo "multitasking" para lograr una vacuna pancoronavirus que ayude a prevenir una próxima pandemia.
"No hay que pensar que con resolver la crisis del covid-19 ya vamos a estar fuera del problema", concluye Bottazzi, "tenemos que seguir buscando alternativas para cualquier emergencia".
Ahora puedes recibir notificaciones de BBC Mundo. Descarga la nueva versión de nuestra app y actívalas para no perderte nuestro mejor contenido.
¿Ya conoces nuestro canal de YouTube? ¡Suscríbete!
Sigue nuestro canal de WhatsApp
Recibe las noticias más importantes del día. Da click aquí